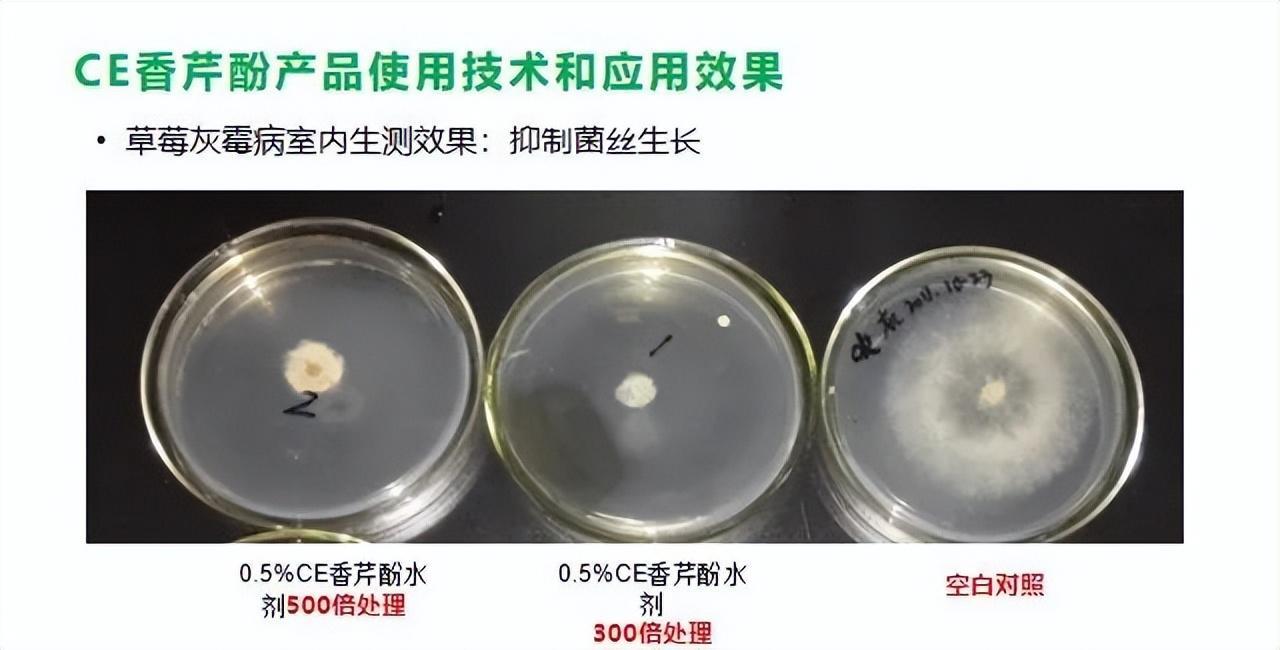

研究表明,香芹酚天然存在于牛至、百里香、冬季香薄荷等唇形科植物的精油中,是一种单萜酚类化合物。目前研究已经证实香芹酚具有抗炎、抗氧化、抗菌多种生物活性,而被广泛用于香料、食品添加剂、饲料添加剂、抗氧剂以及医药中间体等方面,是一种公认的安全广谱的天然抑菌剂。

美国农业部的“植物化学和植物物种学”背景资料表明,牛至含有30多种抑菌化合物,这些成分里面抑菌能力最好的是香芹酚和百里香酚,不但可以杀死真菌或阻止其生长,同时可以抑制多数细菌的生长,而且这种非特异性的抗菌作用不会让细菌产生抗药性。牛至精油中香芹酚是抵抗有害微生物和感染最主要的有效成分,杀菌功能非常强烈,含量最高可占到80% 。
试验证明香芹酚、百里香酚、麝香草酚对镰刀菌属、曲霉菌属、青霉菌属等20种真菌的生长均具有抑制作用,可以较强地抑制真菌生长及真菌毒素合成的作用,可作为一种广谱的抗真菌剂。
香芹酚对真菌、细菌具有广谱抗菌活性,因此,香芹酚也已经被开发和应用到农业病害防治领域。这种酚类化合物不仅具有广谱高效的杀菌作用,还能刺激农作物生长、增强免疫力、提高产量的效果。
目前,成都新朝阳作物科学股份有限公司在2014年,以10%香芹酚母液在农业部药检所登记,成为我国首个香芹酚母液登记生产公司。2015年,以CE0.5%香芹酚水剂再次在农业部取得登记,用于猕猴桃树防治灰霉病、枸杞防治白粉病、枣树防治锈病的防治。
植物源农药CE香芹酚,如何成为灰霉病、白粉病克星?
成都新朝阳的CE香芹酚是以牛至、百里香等多种芳香植物为原料,采取“共提取”工艺提取的含香芹酚、百里香酚等多种活性成分,是一种纯天然的植物源农药制剂,符合有机绿色生产标准。这些植物成分以混合物的形式协同增效发挥抗真菌作用,作用靶点多,使CE香芹酚对作物病害防治不易产生抗性。
杀菌原理:成都新朝阳的CE香芹酚通过其强大的表面活性和脂溶性,抑制病原菌孢子的萌发或迅速穿透病源微生物细胞膜,造成致病源微生物水失衡而死亡。
预防和治疗作用▼▼
成都新朝阳的CE香芹酚对作物灰霉病、白粉病、锈病、炭疽病、斑枯病等真菌病害具有极强的防治效果:如枣树锈病防效达80%~90%、枸杞白粉病防效70%~85%、番茄灰霉病防效达80%~90%;同时,成都新朝阳的 CE香芹酚还对作物具有营养治疗功效,对调节植物生长、提高免疫力,增强抗病性具有调控作用。
CE0.5%香芹酚水剂应用案例▼▼
根据室内以及田间的药效试验结果显示, CE0.5%香芹酚水剂对果实、叶片均无不良影响,同时与化学农药搭配对作物也无不良影响。
CE香芹酚作为天然植物精油抑菌剂,正在被应用到作物有害生物的防控中,可以有效减少化学农药使用量,缓解病虫害抗药性问题。
CE0.5%香芹酚水剂使用技术▼▼
总结
随着人们对食品安全的要求越来越高,香芹酚因其绿色安全、环境友好无残留,以及长期使用无抗药性等优点,将成为绿色、有机、生态农业杀菌剂的首选药剂。